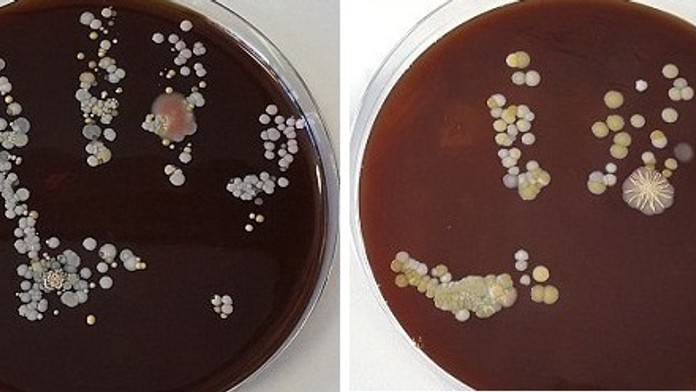
2D8E5F0A00000578-3278935-image-m-58_1445252412113.jpg
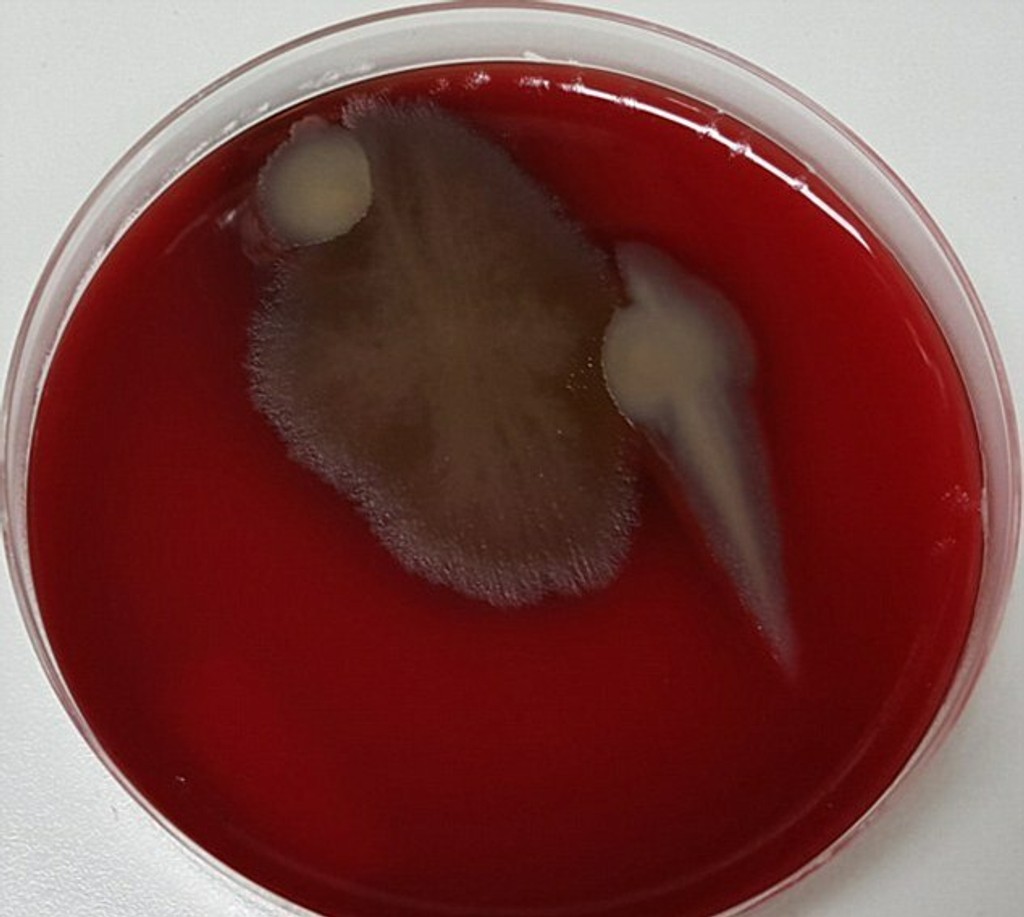
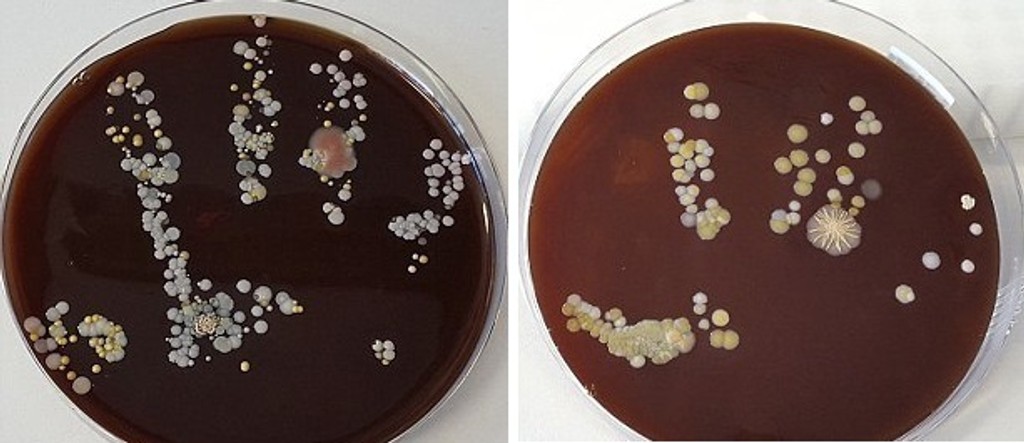
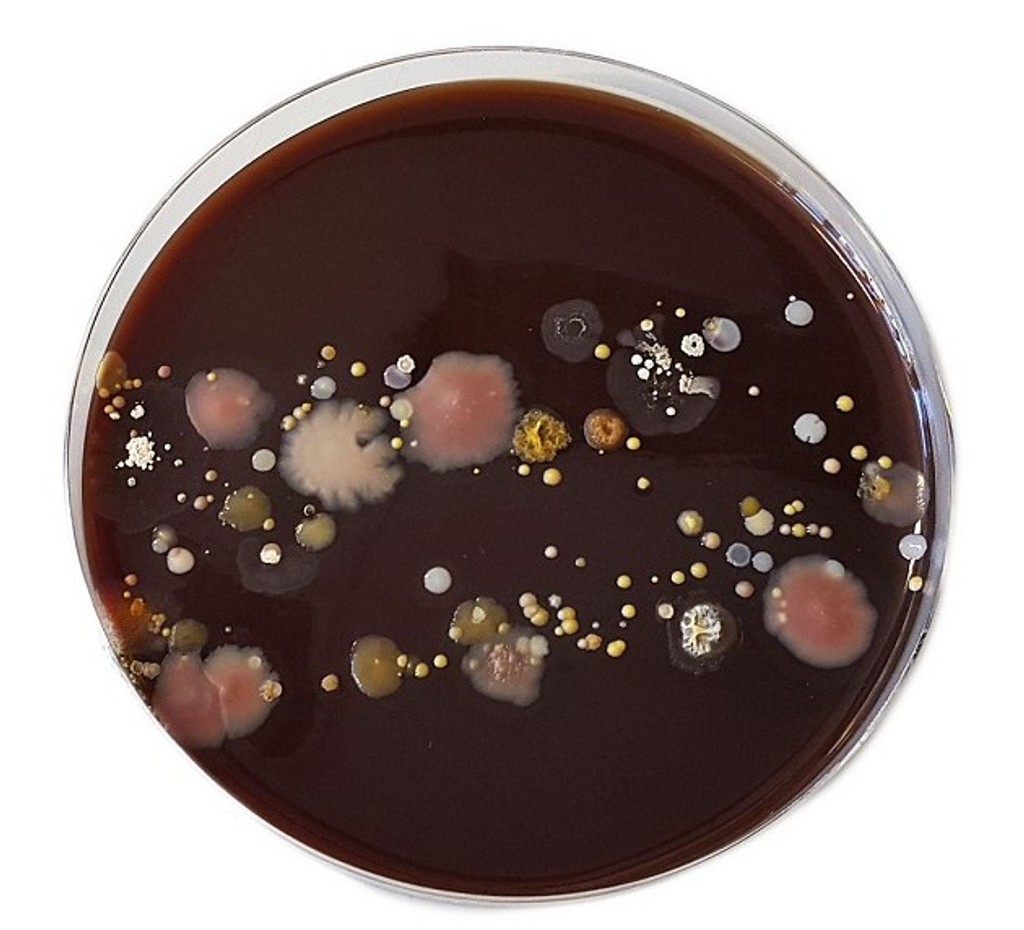

Odporné: Takéto množstvo baktérií nás obklopuje v práci
Chcete pracovať v čistom prostredí? Stačí si umývať ruky.
Ak pracujete v kancelárii, nabudúce si zrejme dvakrát rozmyslíte, či budete jesť pri stole. Priestor okolo počítača vrátane slúchadla telefónu, myšky či klávesnice, bol označený za najnehygienickejšie miesto na pracovisku.
Pracovníci univerzity v Queenslande odhalili šokujúce zábery baktérií, ktoré nás obklopujú v kancelárii. Najčistejšie naopak podľa nich boli kľučky, stoly a stoličky.
Doktor Matt Cooper z univerzity varuje ľudí, aby si počas práce pravidelne umývali ruky. Na antibakteriálne gély máme zabudnúť. Najlepší spôsob zbavenia sa baktérii je obyčajná voda s mydlom.
„Chceli sme upovedomiť ľudí, v akom prostredí pracujú. Je jednoduchý spôsob, ako eliminovať baktérie v kancelárii. Umývať si ruky. Antibakteriálne gély používať neodporúčame, ruky si treba umývať s vodou a mydlom, " vyjadril sa pre denník DailyMail Matt Cooper.
Pozrite si, koľko baktérií obklopuje možno aj vás. Keď prídete ráno do práce, prvé čo by ste mali urobiť, je umyť si ruky.

Sledujte Televízne noviny vo full HD a bez reklám na Voyo

































